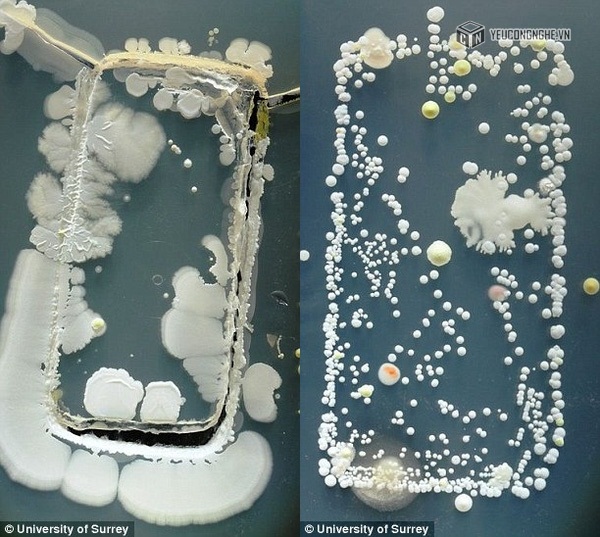

Nhìn thấy những hình ảnh kinh dị thế này có lẽ bạn sẽ xem xét lại việc cầm chiếc điện thoại và để người khác sờ vào điện thoại của mình.
Trong thời đại công nghệ phát triển như hiện nay, chiếc điện thoại thông minh dường như là "vật bất li thân" đối với nhiều người. Bởi chúng đóng vai trò quan trọng trong công việc, giao tiếp, kết nối. Mọi khoảnh khắc đời sống đều cần dùng đến điện thoại như để giải quyết công việc, trò chuyện với bạn bè, gia đình, xem phim, nghe nhạc, cập nhật thông tin,…
Tuy nhiên, có một sự thật đáng sợ về những chiếc điện thoại mà không mấy ai để ý. Một trong những kết quả nghiên cứu gần đây cho thấy số vi khuẩn gây hại trên một chiếc điện thoại nhiều gấp 18 lần so với bồn cầu.
Thông thường, những loại vi khuẩn bám cơ thể người khi ta chạm vào những bề mặt không sạch sẽ hoặc còn sót lại khi khi chúng ta rửa tay không đúng cách đều vô hại. Nhưng một số loại có thể dẫn đến nhiễm trùng, lở loét da và thậm chí là nhiễm trùng huyết.
Để nghiên cứu mức độ bẩn trên bề mặt điện thoại di động, giáo viên chuyên ngành vi trùng học tại Đại học Surrey (Anh) đã yêu cầu sinh viên cho điện thoại vào "môi trường phát triển vi khuẩn" trong các đĩa Petri thí nghiệm. Sau 3 ngày, nhóm nghiên cứu đã phát hiện một kết quả hết sức bất ngờ.
Nút Home và phần xung quanh đường viền điện thoại là nơi “sinh sống” của nhiều loại vi khuẩn nhất.
Trong một số trường hợp, họ phát hiện ra loại vi khuẩn truyền bệnh có tên khoa học là Staphylococcus aureus hay còn gọi là Tụ cầu vàng. Một loại vi khuẩn khác là Trực khuẩn, tên khoa học là Bacillus mycoides. Loại vi khuẩn này thường tìm thấy ở trên mặt đất, vì vậy điện thoại cũng rất dễ mang loại khuẩn này khi nó bị rơi xuống đất.

Hình ảnh hàng triệu con vi khuẩn bám quanh chiếc điện thoại.
Việc làm thí nghiệm này như là một bài tập về nhà cho sinh viên Vi sinh y học do Tiến sĩ Simon Park đưa ra. Ông chia sẻ: "Dường như điện thoại không chỉ là vật trung gian để kết nối giữa người với người mà còn là vật trung gian truyền rất nhiều thứ khác như đất bụi, vi khuẩn gây bệnh và nhiều thứ có hại khác”.
“Tôi ra bài tập hướng dẫn các em cho điện thoại vào đĩa Petri để các em xác định xem điện thoại có thể mang những loại vi khuẩn nào. Có thể cách này khá kỳ lạ nhưng lại là biện pháp tốt để các em không còn dán mắt vào điện thoại di động suốt ngày, khích lệ các em bỏ điện thoại xuống và có nhiều thời gian với cuộc sống thực hơn”.

Điện thoại có thể trở thành vật trung gian truyền bệnh nguy hiểm.
Trong số những chiếc điện thoại mà nhóm sinh viên của Tiến sỹ Park thí nghiệm còn có một trường hợp mang số vi khuẩn đủ để khiến người khỏe mạnh bị rối loạn tiêu hóa nghiêm trọng.
Thậm chí một người đàn ông tại Uganda từng bị nhiễm bệnh sốt xuất huyết do virus ebola gây ra do ăn cắp một chiếc điện thoại di động có chứa vi khuẩn này.
Theo Afamily
Mời bạn xem thêm:
Tại sao không nên cắm điện thoại vào cổng sạc USB?
Vì sao người Nhật không sử dụng điện thoại di động khi đi tàu điện ngầm
8 quy tắc cần biết để sử dụng điện thoại chuyên nghiệp